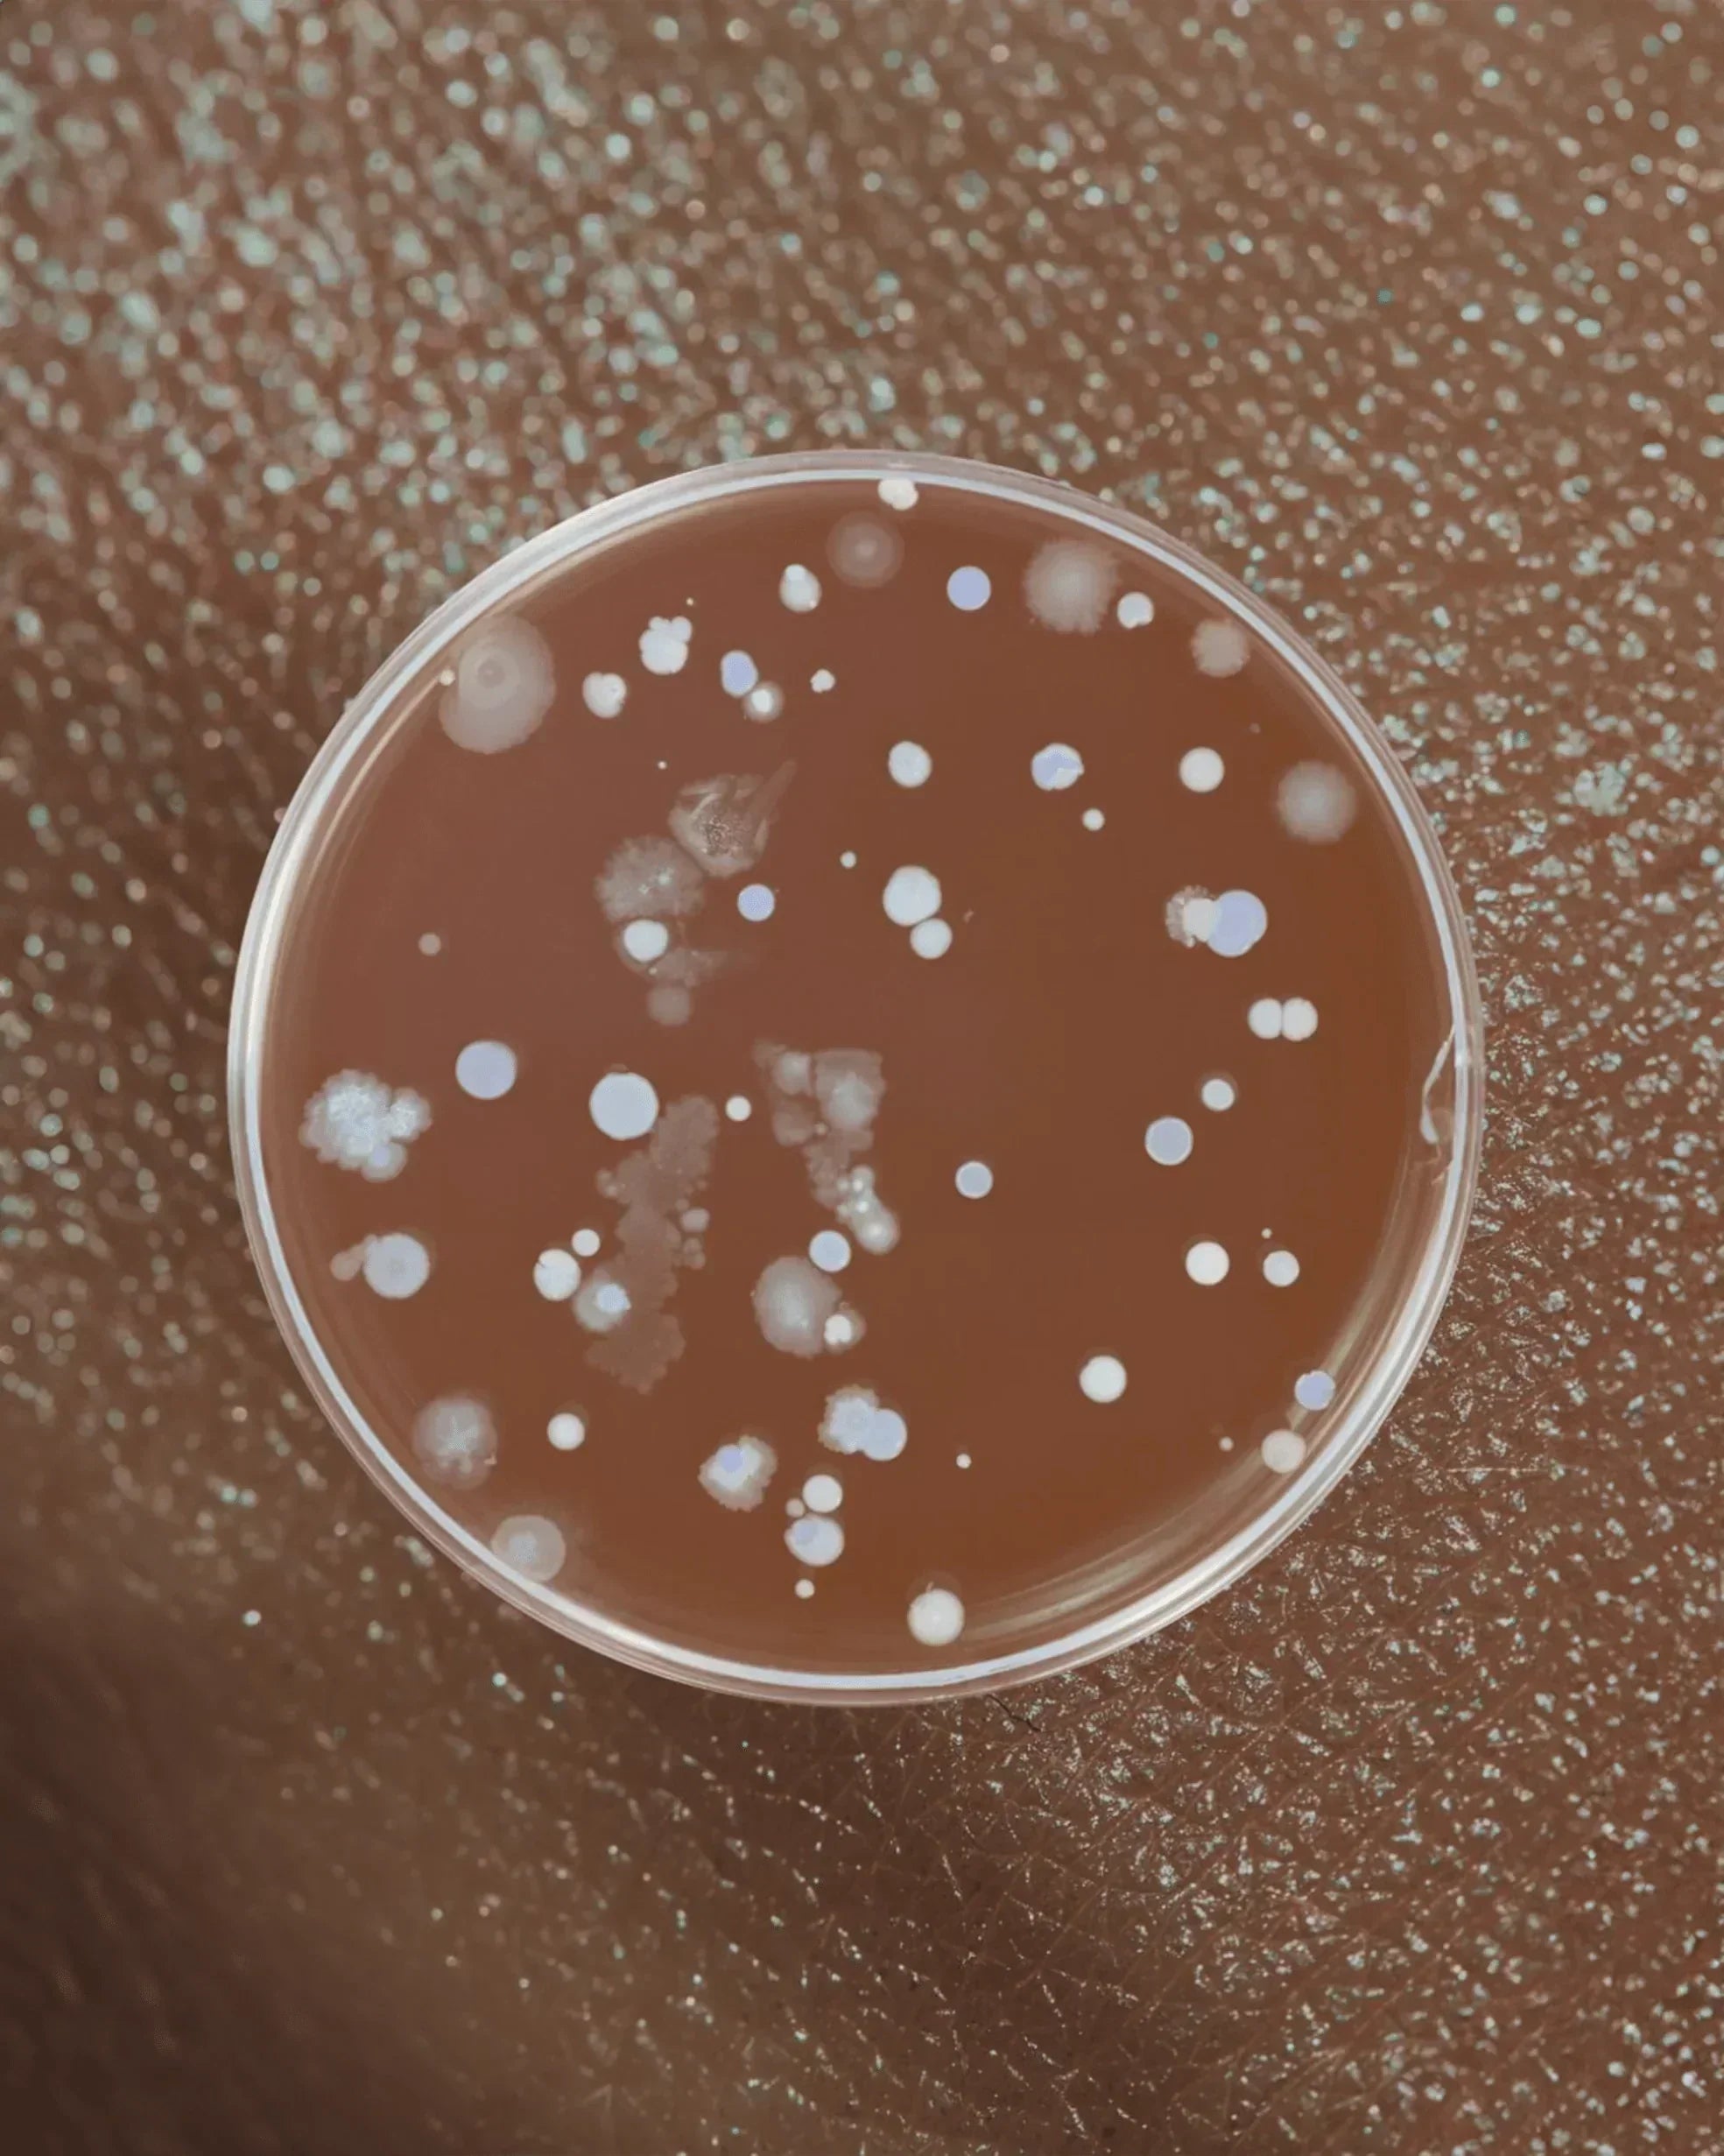
Vaginal Ecology 101: How to Keep Your Microbiome Healthy (And Why It Matters for UTIs) - GOODKITTYCO

uti education

Hell hath no fury like a woman who comes down with a UTI after (let's face it, probably pretty mediocre) sex.

Spoiler: If it burns when you pee, you probably already know the answer.

Low estrogen is a hidden driver of recurrent UTIs—and vaginal estrogen might be the solution you didn't know existed. For the most comprehensive protection, combine vaginal estrogen with Good Kitty...

Why It Happens & How to Prevent It Naturally Discover why sex triggers UTIs in women, the 5-step infection process, and 7 natural prevention strategies including Good Kitty UTI Biome Shield's m...
urinary tract infection preventon

Condoms don’t cause UTIs, but some can make you more vulnerable—especially if you’re already prone to infections. From spermicides to fragrances to friction, here’s what actually increases UTI risk...

Gamechanger in UTI Prevention survival guide: The right way to pee after sex—make it a real flush.

Here's the thing about cranberry supplements that nobody talks about: most of them don't actually work. Not because cranberries are ineffective. Not because the science is bad. But because your bod...

Let's talk about the thing your doctor might suggest when you're on your fifth UTI of the year and both of you are exhausted: prophylactic antibiotics. Translation: taking a low-dose antibiotic eve...

Learn to distinguish between UTI and overactive bladder symptoms, causes, and treatments. Stop misdiagnosis and find the right solution for your frequent urination.

Burning keeps coming back after antibiotics? Learn the difference between recurrent and chronic UTIs, how biofilms cause persistent infections, and what actually helps.

Advanced UTI Protection - While basic d-mannose supplements offer partial benefits, advanced formulations like Good Kitty's UTI Biome Shield with BioblocD3 technology represent the next generation ...

How to buy the best UTI supplements : Purchasing Insights into the Urinary Tract Health Supplement Market.

PACs are the only Active Compound in cranberry supplements for UTIs you should be looking for.
menopause

Menopause isn’t a sudden event — it’s a biological transition that unfolds over years. While the average age is 51, every woman’s timeline is unique. This guide explains when menopause usually begi...
Everything you need to know about preventing urinary tract infections after menopause—with tracking sheets and doctor discussion tools

An ob-gyn explains why postmenopausal UTIs happen—and the most effective treatments to prevent them.

Menopause changes everything—including your UTI risk. Here's the one-two punch that actually works.
pelvic health

BV and UTIs often get confused, but they’re completely different infections that need completely different treatments. Here’s how to spot the symptoms, avoid misdiagnosis, and protect your vaginal ...

BV and yeast infections can flare after antibiotics, sex, or even the wrong lubricant. Here’s what actually causes imbalance—and how gentle, science-backed support like UTI Biome Shield can help ke...
Your vagina is a living ecosystem. Learn how your vaginal microbiome affects UTIs, BV, fertility, immunity, and overall health—and how to keep it in balance.

Your period is more than a monthly inconvenience—it’s a vital sign. Learn what your cycle reveals about hormones, thyroid health, stress, and overall wellbeing.

Here's a fun fact nobody tells you: the period products marketed as "natural," "organic," and "non-toxic" might be poisoning you.

If you're pregnant, trying to get pregnant, or recently had a baby, here's something nobody probably warned you about: your risk of getting UTIs just skyrocketed.

The Estrobolome: Your Gut Bacteria Are Running Your Hormones (And They Need a Raise) Estrogen 101 What’s Your Gut Got to Do With It? Meet Your Estrobolome Trouble in Paradise What Causes Dysbiosi...

Recent research confirms what many women have long suspected: your gut, bladder, and vaginal health are deeply connected. This system is known as the gut–urogenital microbiome axis, and understandi...

